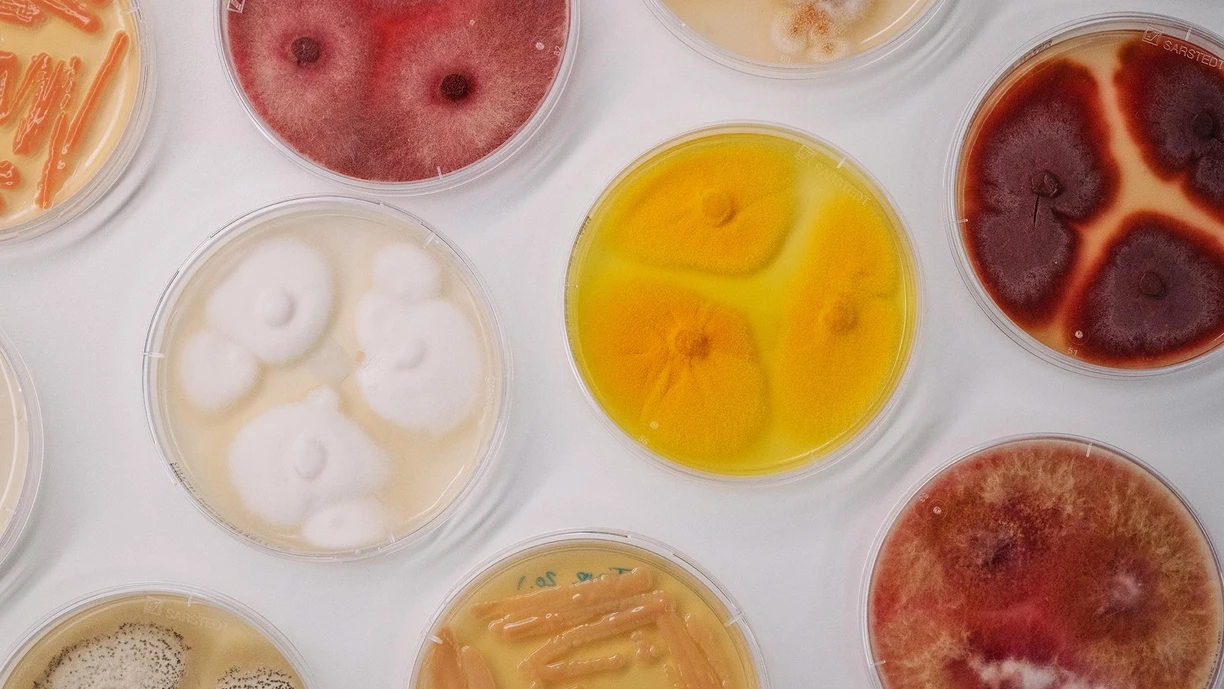
lab-fungi-petri-dish-Lyngby-DK-001

Biosolutions let you get more from animal protein
More animal protein, less waste
Enzymes are your key to getting the most out of animal proteins. They’ll increase quality and yield and improve your sustainability while reducing waste.
Your environmentally friendly processing aids
Enzymes convert proteins from a variety of sources, including animal by-products, into valuable sources of protein. Enzymatic protein hydrolysis solubilizes meat coproducts by converting them into protein hydrolysates. The proteins have been at least partially broken down into small peptides and amino acids.

Boost value with more enzymes
Enzymes are specific. Each one catalyzes a specific reaction. Applying a combination of enzymes gives you more benefits. It also allows you to meet specific commercial goals. That's why more enzymes can translate into higher-value end products.
Meat protein extracts
MPEs improve the flavor and texture of meat cuts, processed foods, soups, sausages and other foods.

Seafood protein extracts
Seafood protein extracts are hydrolyzed fish proteins. You can use them as natural flavors and flavor enhancers.

Collagen peptides
Collagen peptides are derived from skin, bone and connective tissue, often through gelatin. And they are sometimes referred to as hydrolyzed gelatin. Bioactive peptides based on collagen are associated with a number of health benefits.

Feather hydrolysates
Also called protein hydrolysates from feathers, they are a valuable source of protein in the animal feed industry.

Pet food palatants
Convert animal co-products into valuable pet food palatants. With biosolutions, boost productivity to cut costs while maintaining quality.

Unlock value from animal sources
Enzymatic processing lets you unlock valuable components from animal sources. GAGs support medical, veterinary, pharmaceutical, and cosmetic products.

Expand your protein sources
Yeast proteins are high quality and can be extracted via enzymatic hydrolysis for diverse applications beyond flavoring, including from cell-wall sidestreams. Insect proteins are also gaining interest for their nutrition and sustainability, with enzymes improving process consistency.

There’s a biosolution for all your needs
Get in touch
Have questions? We’d like to hear more about what you need.
One more step…
To complete the get in touch form or sign up, please click on the button below to enable cookies.
You might also be interested in:
Biosolutions are useful in a broad range of applications. Here a just a few.

Plant-based meat
Discover how to use our biosolutions to unlock the answers to creating better plant-based meats from inside your raw materials.

Pet food
Probiotics, microbial biosolutions and enzymes offer a natural way to create differentiated and innovative pet food, treats and supplements—supporting pet health and well-being, enhancing product palatability, and optimizing production efficiency.

Meat
Our biosolutions for meat help ensure your meat delivers on taste, safety and sustainability.